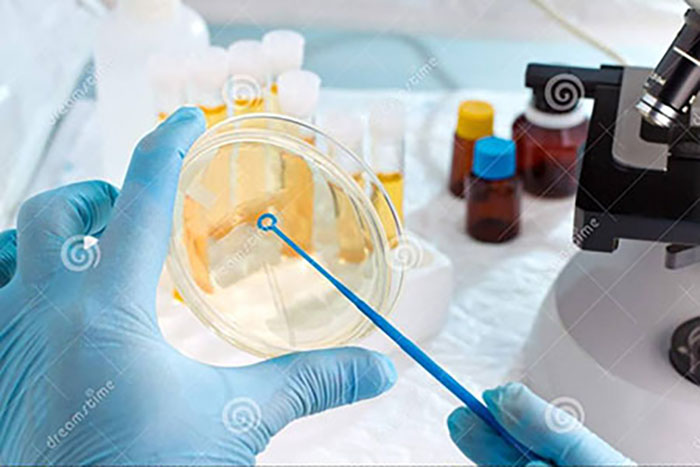

Welcome to the website of Changzhou Kelier Chemical Co., Ltd.

Add: Room 336, Building 2, Zhishi Commercial Plaza, No. 600-1, Tongjiang Middle Road, Xinbei District, Changzhou City, Jiangsu Province
E-mail: sales@korelchem.com
2018 Changzhou Kelier Chemical Co., Ltd. Copyright
Record number: 蘇ICP備18065962號(hào)
Website navigation
QR code
